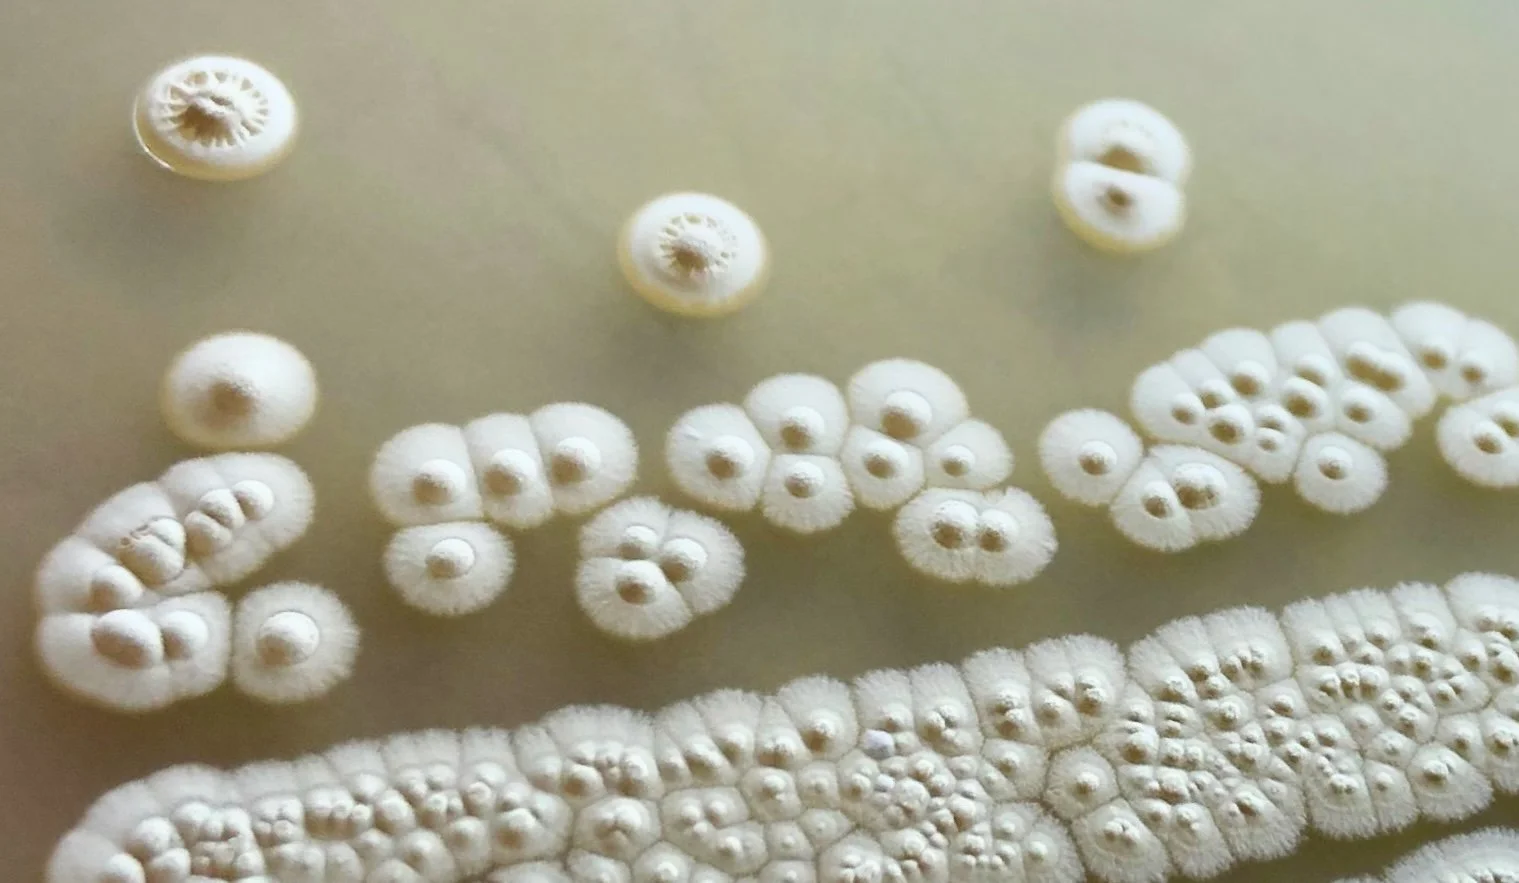

2026 mim_c Spring Symposium - Registration Form
Tuesday, May 19th, 9:00am - 12:00pm
UW South Campus Center, Seattle






Tuesday, May 19th, 9:00am - 12:00pm
UW South Campus Center, Seattle